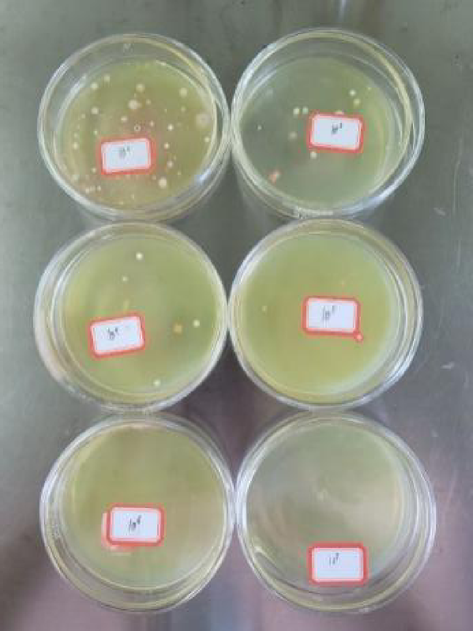
Fig. 3

Abstract
Microbially induced carbonate precipitation (MICP) has proven to be an effective method for soil reinforcement. Sporosarcina pasteurii is widely used due to its high urease activity. However, being an alkaliphilic bacterium, its limitations in acidic soil environments tend to be overlooked. This study isolated a native urease-producing bacterial strain Bacillus aryabhattai with acid tolerance, and comparative analysis of the growth characteristics of B. aryabhattai and S. pasteurii. The grouting and spraying techniques were employed to reinforce granite residual soil by the B. aryabhattai and the S. pasteurii, and the reinforcement mechanisms were systematically investigated. Experimental results indicated that despite exhibiting slightly lower urease activity and growth, the indigenous urease-producing bacterium B. aryabhattai demonstrated superior environmental resilience in terms of both environmental temperature and pH range. The soil samples reinforced by grouting with B. aryabhattai and S. pasteurii exhibited increases in ultrasonic wave velocity, unconfined compressive strength, cohesion, and cumulative disintegration rate to varying degrees compared to the untreated soil samples. Meanwhile, the resistance value of the soil samples reinforced by spraying with B. aryabhattai and S. pasteurii decreased by 84.39% and 79.79%, respectively. Additionally, the calcium carbonate content in the upper section of soil reinforced with B. aryabhattai was comparable to that of S. pasteurii; however, while in the lower section, it exhibited a 36.22% higher precipitation rate than the S. pasteurii-treated soil. Overall, the indigenous strain B. aryabhattai demonstrated remarkable reinforcement effectiveness, attributed to its rapid adaptation to weakly acidic soil conditions and moderate urease activity, which promoted a homogeneous distribution of calcium carbonate. These findings provide significant insights for soil reinforcement applications through MICP.
Similar content being viewed by others
Introduction
In the mountainous regions of South China, granite exposures account for 30%–40% of the area, resulting in numerous granite cutting slopes1,2,3. Upon weathering of granite, a substantial amount of its feldspar component undergoes hydrolysis and carbonation to form kaolinite4,5. Kaolinite expands and softens upon contact with water, which triggers slope collapse and landslide, particularly during periods of heavy rainfall. Current disaster prevention and mitigation strategies rely primarily on engineering methods and vegetative approaches. Engineering methods often involve reinforcement techniques, such as anchoring and the use of geosynthetic reinforced soil, and provide a certain extent of protection6,7; however, they involve complex construction processes and do not fully align with green and low-carbon principles. Although vegetative slope protection offers ecological benefits, it is costly because of the possibility of erosion before seed germination and the need for extensive postgrowth management8. Additionally, the application of vegetative slope protection is limited with respect to steep slopes9. Consequently, new, environmentally friendly reinforcement methods suitable for granite residual soil slopes must be explored.
In recent years, microbial-induced calcite precipitation (MICP) technology has attracted considerable attention as an innovative and environmentally friendly approach for soil reinforcement10,11. MICP employs high-yield urease-producing bacteria to decompose urea, with an external introduction of ample calcium sources, causing the rapid formation of substantial amounts of calcium carbonate12. This process binds loose soil particles together, reduces interparticle porosity, and enhances soil strength. MICP offers unique advantages compared with traditional reinforcement methods; for instance, calcium carbonate, a cementing agent, is more stable than several artificial materials, offering advantages in terms of durability, and has a lower environmental impact13. Studies on the solidification of various soil types—including silty soil14, expansive soil15, and dredged fill16—have shown that factors such as colony distribution, initial bacterial concentration, and standing time are key to effective solidification, although the suitable reinforcement methods may differ for each soil type17. These findings have considerably advanced the application of MICP technology in soil reinforcement.
The application of MICP technology in granite residual soil has been confirmed by several researchers. Reinforced soil exhibits shear strength comparable to that of soil samples improved with traditional lime cement. Additionally, it shows enhanced permeability, erosion resistance, and disintegration resistance18,19. Zhu et al.20 improved the microbial growth environment by incorporating calcium lignosulfonate, which substantially refined the pore structure of granite residual soil, resulting in a maximum increase of 41.2% in compressive strength. Feng et al.21 conducted a detailed analysis of the impact of clay content on the effectiveness of MICP curing and observed a 9%–16% increase in shear strength when the clay content ranged from 10% to 40%. Our previous studies have demonstrated that dual-media techniques can greatly enhance the urease activity of bacterial strains. In addition, we investigated various reinforcement methods, such as soaking, peristaltic pumping, and air compression, to assess their impact on the uniform distribution of calcium carbonate deposition22. Although these studies provide valuable experimental data for reinforcing the surface and shallow areas of granite residual soil slopes, the practical application of MICP technology under such conditions faces considerable challenges.
Granite residual soil exhibits distinct regional characteristics23. For example, granite residual soils in southern China generally exhibit weak acidity due to their parent rock composition and climatic conditions. Currently, S. pasteurii is primarily utilized for soil reinforcement, with its notable advantage being its high urease activity24. The urease activity of this strain is typically quantified by measuring the amount of urea decomposed per unit time, which is a key factor directly influencing the mineralization effect of MICP25. However, S. pasteurii is an alkalophilic bacterium that thrives in a pH range of 8–912. Teng et al.26 used S. pasteurii to stabilize acidic silty clay soils, observing a doubling in shear strength after 3 days of curing. To enhance the effectiveness of MICP technology in acidic marine soils, Saad et al.27 combined MICP with the electrokinetic phenomenon, achieving notable improvements in treatment outcomes. These findings demonstrate that MICP technology can also be applied in acidic soils. However, how to effectively enhance MICP’s stabilization efficacy and promote its field-scale application remains a pressing challenge. In recent years, progress has been made in MICP stabilization using indigenous strains. Indigenous strains not only exhibit natural tolerance and adaptability to local environmental conditions such as pH and temperature but also possess excellent mobility and colonization capabilities in soil, facilitating uniform distribution in deep soil matrices28. Therefore, this study proposes starting with the isolation of indigenous strains to improve the stabilization effectiveness of weakly acidic granite residual soil. The following key questions require clarification: (1) whether it is possible to isolate a strain with high urease activity adapted to a weakly-acidic environment from the local soil? (2) whether the soil solidification performance of native strains is superior to that of S. pasteurii with high urease activity? (3) what is the mechanism by which MICP reinforces weakly-acidic soil?
To address these problems, this study first extracted indigenous urease-producing bacterial strains and conducted a comparative analysis of their growth characteristics using S. pasteurii as a reference. Then, grouting and spraying techniques were employed to reinforce the soil, and the effectiveness of this reinforcement was evaluated. Finally, the mechanisms underlying MICP’s reinforcement of weakly acidic soil are elucidated, and the limitations of the current research, along with areas meriting further investigation, are summarized. These findings provide novel insights into MICP-reinforced soil from the perspective of balancing bacterial urease activity and environmental adaptability.
Materials and methods
Experimental materials
The urease-producing bacteria employed in this experiment were indigenously isolated, with S. pasteurii (purchased from the China General Microbiological Culture Collection Center(CGMCC), number 1.3687) serving as a reference for comparison.
The medium used for S. pasteurii comprised yeast extract (20 g/L), ammonium chloride (10 g/L), and nickel chloride (0.05 g/L). The medium used for B. aryabhattai comprised peptone (10 g/L), yeast extract (5 g/L), and sodium chloride (10 g/L).
The soil samples used in this research were collected from the roadside slope at stake K1347 of the National Highway 237 in Wuyishan, China (Fig. 1). In accordance with the Chinese Standard GB/T 50,123 − 2019 (Geotechnical Testing Methods) and ISO 10,390: 2005 (Soil quality-Determination of pH), the physical parameters of the soil samples were tested, as detailed in Table 1. The result shows that the pH value of soil samples was 5.3 (weakly acidic), which poses challenges for the growth of the conventional MICP strain. The particle size distribution of the granite residual soil was determined using the sieve analysis method combined with a laser particle size analyzer, and the result is shown in Fig. 2. The coefficient of uniformity (Cu) and the coefficient of curvature (Cc) of the soil samples were 12.4 and 1.42, respectively, indicating that indicating that the soil can be classified as a low-liquid-limit soil with a poorly graded texture. Specifically, the grain size distribution is dominated by sand and gravel, with silt and clay comprising 12.69% of the total mass.
(a) Granite residual soil slope; (b) Granite residual soil slope rock structure.
Cumulative particle size distribution of soil.
Test method
Isolation and identification of Indigenous urease-producing bacteria
Based on the nitrogen-attracting characteristic of urease-producing bacteria, soil from the root zones of lush vegetation was selected for bacterial isolation. Subsequently, the urease-producing bacteria were enriched in a culture medium with high urea content, followed by dilution and isolation on the same medium (Fig. 3). The initially isolated bacteria were screened a second time using phenolphthalein as an indicator to select target colonies, with Solid Medium No. 1 as the control (Fig. 4). Finally, the biological density and urease activity of the bacterial strains were compared, and indigenous strains with high urease activity were selected for use in this experiment.
The urease-producing bacteria were enriched in a culture medium.
Using phenolphthalein as an indicator to select target colonies.
Bacterial identification was performed using 16 S rDNA sequence analysis. After extracting genomic DNA from the dominant strains, polymerase chain reaction (PCR) amplification of the 16 S rDNA gene was performed using the primers 27 F and 1492R. The purified PCR product was then subjected to DNA sequencing using the ABI3730-XL sequencer. When the 16 S rDNA sequence homology exceeds 97%, the strain is considered to be the same species within the genus.
The mineral composition of calcium carbonate precipitates was tested using X-ray diffraction (XRD; D8 advanced, Bruker) with Cu–Kα radiation. The scanning range was 10°–80° (2θ) with a scanning rate of 2°/min. The morphology of the calcium carbonate precipitates was characterized using scanning electron microscopy (SEM; VEGA3, TESCAN), with an acceleration voltage of 15 kV.
Comparative analysis of the growth characteristics of bacterial strains
The experiment analyzed the sensitivity factors affecting the growth of the two urease-producing bacteria by varying the culture medium, inoculation amount, pH, incubation temperature, and shaker frequency. The experimental procedure is detailed in Table 2.
Reinforcement test of granite residual soil
The two types of urease-producing bacteria were cultured for 40 h under the optimal growth conditions determined in Sect. “Comparative analysis of the growth characteristics of bacterial strains”, and the soil sample was further reinforced by employing grouting and spraying methods.
-
(1)
Grouting method
This experiment was designed to simulate the grouting and solidification of the shallow layer (5–20 cm) of granite residual soil, which serves as an experimental reference for shallow reinforcement of slopes. The test scheme is presented in Table 4. The experiment was conducted in an indoor environment at 28 °C. Initially, the soil sample was incrementally loaded into a mold and compacted. Subsequently, a bacterial solution (OD600 = 1.5) equivalent to one pore volume was injected into the soil sample at a rate of 5 mL/min. This was followed by the injection of a 0.5 mol/L calcium chloride fixing solution, amounting to 1.1 times the pore volume, at the same injection rate. After the injection, the sample was left to stand for 4 h. Then, a cementation solution, with a volume three times the pore volume, was introduced into the soil sample at a rate of 1 mL/min. Finally, the sample was allowed to stand for 12 h to complete one cycle of grouting. After six rounds of grouting, the samples were cured at 30 °C under 31% humidity for 7 days before demolding. The detailed experimental procedure is provided in Table 3.
-
(2)
Spraying method
This experiment aimed to simulate the surface spray solidification of granite residual soil, providing an experimental reference for preventing rain splash erosion and scouring on the surface layer (0–5 cm) of granite residual soil. The test scheme is detailed in Table 4. The experiment was conducted in an indoor environment at 28 °C. The culture medium used had an OD600 of 0.8, and the cementation solution (a mixture of urea and calcium chloride) had a concentration of 0.5 mol/L with a pH of 8.5. Initially, a bacterial solution equivalent to one pore volume was sprayed onto regions I and III, followed by a 2-h resting period. Subsequently, a 0.5 mol/L cementation solution, amounting to three times the pore volume, was sprayed and left to stand for 12 h. This process was repeated three more times, with each application followed by a resting period of 12 h. In region II, the bacterial solution and cementation solution were replaced with an equivalent volume of deionized water, and the grouting procedure remained consistent with that of regions I and III. After the completion of the experiment, the samples were left to stand at 28 °C for 14 days before the commencement of experimental testing.
Evaluation of the effectiveness of grouting reinforcement
Nondestructive testing
Nondestructive testing employs a nonmetallic ultrasonic velocimeter to calculate the wave velocity of ultrasonic waves in the medium using the time difference method to evaluate the reinforcement effect. A higher wave speed indicates that the sound wave encounters less resistance during propagation; moreover, a denser medium indicates tighter connections between soil particles.
Strength
Shear stress and UCS tests were conducted in accordance with the Chinese National Standard for Geotechnical Testing Methods GB/T 50,123 − 2019. Shear stress was measured at a shear rate of 0.8 mm/min under vertical pressures ranging from 100 to 400 kPa.
Disintegration rate
Considering the actual engineering conditions of granite residual soil slopes, which are prone to mountain landslides under frequent drying–wetting cycles, the disintegration rate test was performed as follows. The samples were first dried at 60 °C until they reached a constant weight and then soaked in water. Residual soil samples were removed for drying every 4 h, and the quality of dried samples was recorded. This process was repeated 6 times to complete the disintegration test.
Evaluation of the effectiveness of spraying reinforcement
Resistance
The current flowing between two metal grids was measured using a digital bridge (frequency: 100.00 kHz, level: 1.00 V, bias: 1.00 mV). The resistance (R) of the solidified soil sample was calculated according to formula (1).
where U, I, and R represent the voltage (V), current (A), and resistance (Ω), respectively.
Next, the relationship between the cross-sectional area and resistance was analyzed using formula (2) to determine the compactness of the solidified soil sample.
where R indicates the resistance, L indicates the length (m) between the electrodes, S indicates the cross-sectional area (m2), and \(\rho\) indicates the resistivity (Ω·m).
Production of calcium carbonate
After stabilization, the amount of calcium carbonate generated in the solidified residual soil was determined using the acid washing method. Five portions of 10 g each from the upper and lower parts of the solidified soil samples were placed in a beaker. An excess of 1mol/L hydrochloric acid was added repeatedly until no bubbles were generated. After filtration, the samples were dried in an oven at 105 °C until a constant weight was reached, and the remaining sample mass was recorded. The calcium carbonate content was calculated according to formula (3).
where W indicates the calcium carbonate content and m indicates the mass of the remaining soil sample.
Micro-analysis
The composition and crystal morphology of the mineralized products were analyzed using XRD, and the microstructure of the solidified soil was examined using SEM. The instrument parameters were set as described in Sect. “Isolation and identification of indigenous urease-producing bacteria”.
Result and analysis
Bacterial identification
Three genetically stable, urease-active bacterial strains were isolated from soil in Wuyishan, China; their biological characteristics are presented in Table 5. The OD600 of the UR1 strain was 1.543, and its urease activity was 36.55 mM/min, which were 8.26% and 6.69% lower than those of the reference strain, respectively. These results indicate that the UR1 strain has high biological density and urease activity; therefore, it can be initially selected as the dominant urease-producing strain. After pouring the UR1 and reference strains into a calcium chloride–urea mixed solution (0.5 mol/L) and incubating the mixture at 30 °C for 48 h, a large amount of calcium carbonate precipitate was observed (Fig. 5). XRD analysis of the precipitates (Fig. 6) revealed that the crystal forms induced by the indigenous urease-producing bacteria were identical to those of the reference strain, with pronounced diffraction peaks appearing between 29.4° and 29.6°. Thus, the calcium carbonate induced by the indigenous urease-producing bacteria, similar to that induced by S. pasteurii, is the most stable calcite form. Electron microscopy analysis (Fig. 7) further demonstrated that the indigenous bacteria and the calcium carbonate precipitates induced by S. pasteurii exhibited regular hexagonal calcite crystal shapes, with only a small proportion displaying round vaterite. These results indicate that the indigenous urease-producing bacteria possess optimal calcium carbonate precipitation capability and are suitable for use in this experiment. After 16 S rDNA analysis, the urease-producing bacterium exhibited 99.7% DNA sequence similarity with Priestia aryabhattai B8W22 (Bacillus aryabhattai, genus Bacillus, gram-positive, with biological activities including nitrogen fixation, phosphorus solubilization, and silicon solubilization), indicating that they are the same strain.
Calcium carbonate precipitation by: (a) S. pasteurii; (b) B. aryabhattai.
XRD patterns of calcium carbonate precipitation induced by: (a) S. pasteurii; (b) B. aryabhattai.
SEM images of calcium carbonate precipitation induced by: (a) S. pasteurii; (b) B. aryabhattai.
The key to MICP technology is that the selected microbial urease activity must be sufficient to rapidly decompose urea, and provided an adequate calcium source, generate a substantial amount of calcium carbonate. Relevant studies have demonstrated that S. pasteurii is widely used in MICP due to its high urease activity24,29,30. The urease activity of the isolated indigenous B. aryabhattai is comparable to that of the reference strain, indicating that it possesses superior urease activity. Moreover, the strain induces the formation of calcite-type calcium carbonate, the most stable form, thus meeting the application requirements of MICP technology.
Comparative analysis of the growth characteristics of bacterial strains
Influence of culture medium
As shown in Fig. 8, the two types of urease-producing bacteria exhibited considerable differences in their preferred nutrient compositions. S. pasteurii is generally adaptable to all four culture media, with superior growth observed in YE and LB media. These media contain high levels of amino acids and polypeptides, which serve as fundamental energy sources. Further analysis of the OD600 values after the stationary phase indicated that YE medium was optimal for S. pasteurii. In contrast, AN and 907 media were completely unsuitable for B. aryabhattai, which thrived only in YE and LB media. This behavior is primarily due to the higher content of nitrogenous substances in the LB medium. B. aryabhattai, originally isolated from near plant roots 20 cm below the soil surface, exhibits a strong ability to absorb and transform nitrogenous substances31,32. Therefore, LB medium is considered optimal for the indigenously isolated B. aryabhattai.
Effects of culture medium on bacterial growth: (a) S. pasteurii; (b) B. aryabhattai.
Influence of inoculation volume
The effect of different inoculation volumes on the growth of the two urease-producing bacteria is illustrated in Fig. 9. A larger inoculation volume confers an advantage during the lag phase of growth for both strains; however, this benefit gradually diminishes during the stationary phase. This is because increased inoculation leads to growth inhibition of urease bacteria by their own metabolic waste33,34. Consequently, an inoculation amount of 1% was considered optimal for both bacterial strains.
Effect of inoculation volume on bacterial growth: (a) S. pasteurii; (b) B. aryabhattai.
Influence of culture medium pH value
The effect of different pH values of the culture medium on the growth of the two urease-producing bacteria is shown in Fig. 10. Both strains displayed notable intolerance to the environment at pH 10. S. pasteurii exhibited markedly better growth at pH 8 and pH 9 than at pH 6 and pH 7, indicating a preference for moderately alkaline conditions. In contrast, the growth trends of B. aryabhattai at pH 6, pH 7, and pH 8 were generally similar, indicating its adaptability to weakly acidic, neutral, and weakly alkaline conditions. However, a considerable growth retardation was observed at pH 9, lasting approximately 20 h. Following this stable period, B. aryabhattai adapted to the environment at pH 9 and eventually exhibited an optimal growth state, reflecting its strong environmental adaptability.
Given that the pH range of the soil reinforced in this experiment is 5.3, this study focused on comparing the growth of the two strains at pH 6. S. pasteurii exhibited a growth lag of approximately 30 h and had not entered the stable growth phase even after 50 h. In contrast, B. aryabhattai, benefiting from its indigenous origin, quickly adapted and entered the logarithmic growth phase. This rapid adaptation may be attributed to the bacterium’s ability to regulate cell membrane permeability, modify enzyme activity, and produce specific metabolites to maintain intracellular stability35, thereby enabling sustained growth and reproduction under low-pH conditions.
Effect of culture medium pH value on bacterial growth: (a) S. pasteurii; (b) B. aryabhattai.
Influence of cultivation temperature
The effects of different cultivation temperatures on the growth of the two urease-producing bacteria are shown in Fig. 11. S. pasteurii grows and reproduces rapidly at temperatures between 25 and 35 °C; however, at 40 °C, a brief lag phase was observed within the first 10 h, whereas at 20 °C, a prolonged lag phase of up to 25 h was observed, accompanied by a reduced logarithmic-phase growth rate. Overall, these findings indicate that S. pasteurii exhibits low tolerance to colder temperatures.
B. aryabhattai demonstrated rapid adaptation within the cultivation temperature range of 30–40 °C. At 20–25 °C, a brief lag phase was observed before the initiation of normal growth, after which the strain exhibited enhanced performance during the stable growth phase. These results suggest that B. aryabhattai possesses a broader temperature tolerance range and stronger adaptability to lower temperatures.
Effect of cultivation temperature on bacterial growth: (a) S. pasteurii; (b) B. aryabhattai.
Influence of shaker frequency
The effects of shaker frequency on the growth of the two urease-producing bacteria are shown in Fig. 12. As typical aerobic microorganisms, both strains responded to changes in oscillation frequency. S. pasteurii achieved the fastest initial growth rate at 200 rpm, whereas B. aryabhattai exhibited a shorter lag phase before entering the logarithmic phase as the shaker frequency increased. Based on OD600 values during the stable growth phase, an optimal oscillation frequency of 150 rpm was determined for both strains.
Effect of shaker frequency on bacterial growth: (a) S. pasteurii; (b) B. aryabhattai.
Sensitivity analysis
A sensitivity analysis was conducted using the OD600 values after 28 h of cultivation of urease-producing bacteria under standard conditions (30 °C, pH 8.0, 200 rpm, and 2% inoculation)25,36. As shown in Fig. 13, both strains exhibited high sensitivity to a highly alkaline environment (pH = 10). In addition, S. pasteurii exhibited high sensitivity to a weakly acidic environment (pH = 6) and lower temperatures (20 °C). Overall, B. aryabhattai demonstrated stronger environmental adaptability.
Analysis of bacterial growth condition sensitivity.
Analysis of the reinforcement effect of the grouting method
The grouting reinforcement method is illustrated in Fig. 14(a). The soil sample was placed in an acrylic mold, and both the bacterial and cementation solutions were injected using a peristaltic pump. The cured soil samples, as shown in Fig. 14(b), showed dimensions of 50 × 100 mm and 61.8 × 20 mm, respectively. The reinforcement effect was evaluated based on parameters such as the ultrasonic velocity, compressive strength, and disintegration rate of the soil samples.
Ultrasonic velocity and UCS
The 50 × 100-mm soil samples were subjected to ultrasonic velocity testing and UCS testing, as detailed in Fig. 14(c)–(f). As shown in Fig. 14(f), both urease-producing bacteria effectively consolidated the granite residual soil. The average wave velocity of the soil samples solidified with B. aryabhattai was slightly higher, reaching 1209 m/s, than that (1108 m/s) of the soil samples solidified with S. pasteurii. Compared with the average wave velocity of untreated residual soil (508 m/s), the soil samples reinforced by grouting with B. aryabhattai and S. pasteurii showed increases of 137.99% and 118.11%, respectively. This indicates that the compactness of the soil samples improved considerably after solidification. The isolated B. aryabhattai demonstrated a slightly superior reinforcement effect, with a 9.12% higher wave velocity than S. pasteurii, suggesting its advantage in consolidating indigenous soil.
Based on the UCS results shown in Fig. 14(f), the average compressive strength of sample M1 was 1.422 MPa, whereas that of sample Z1 was 1.675 MPa. Compared with the untreated residual soil sample D1, which had an average compressive strength of 0.269 MPa, the compressive strengths of M1 and Z1 increased by 428.62% and 522.68%, respectively. These results confirmed that both granite residual soil samples were effectively solidified. Although S. pasteurii exhibited slightly higher biological density and urease activity than B. aryabhattai, the compressive strength of sample M1 was only 85.81% of that of sample Z1. The unconfined compression failure processes of samples M1 and Z1 are depicted in Figs. 14(d) and (e), respectively. Under vertical loading, the lower region of sample M1 yielded and fractured first; after unloading, the upper part maintained a high degree of integrity, indicating that calcium carbonate cementation was considerably higher in the upper portion than in the lower. The calcium carbonate distribution in sample M1 was relatively uneven, exhibiting a pronounced one-dimensional characteristic. Under vertical loading, sample Z1 exhibited distinct brittle characteristics; cracks originated at the bottom of the sample and gradually propagated upward, eventually forming a penetrating crack. This failure mode is consistent with the uniaxial compressive failure pattern observed in brittle materials, and it can be preliminarily inferred that the calcium carbonate content in sample Z1 is more uniformly distributed than that in sample M1.
The uniform distribution of calcium carbonate directly affects the strength of the solidified specimens. The uneven distribution of calcium carbonate in sample M1 is attributable to several factors. First, due to the varying grain sizes of the granite residual soil, the proportion of fine and clay particles below 0.075 mm exceeds 15%. During grouting, the pores and throats between soil particles tend to trap microorganisms, resulting in a reduced distribution of microorganisms from the top to the bottom of the consolidated soil25. Second, the tested soil samples were weakly acidic. Furthermore, the growth characteristics of S. pasteurii indicated that the bacterium exhibits an extremely long lag phase in an environment at pH 6. This may result in fewer bacteria attaching and growing normally in the lower section of sample M1 during the first 1–2 rounds of grouting. Consequently, the bacteria’s ability to decompose urea in the cementation solution remains insufficient, leading to lower calcium carbonate production in the lower section during the initial stages of grouting. As the number of grouting cycles increases, the pH value along the reinforced soil sample gradually rises with the relative seepage length. This gradual increase in soil pH promotes the growth rate of S. pasteurii, inducing its high urease activity37. The rapid decomposition of urea then results in the formation of abundant calcium carbonate precipitates and a sharp increase in calcium carbonate crystallization at the top of the sample. This further enhances the trapping of microorganisms, causing a considerable disparity in the calcium carbonate content between the upper and lower parts of the sample. Consequently, the soil sample exhibits a pronounced one-dimensional characteristic.
Shear strength
As shown in Fig. 14 (g)–(i), the shear strength of the granite residual soil samples after solidification was higher than that of the unreinforced samples. Calcium carbonate precipitation effectively promotes interconnection between soil particles and contributes to shear strength. After reaching the peak shear stress, a cliff-like drop occurs, mainly due to the failure of connections between soil particles under overload, leaving only the interlocking force along the shear plane. Under the same vertical load, sample Z2 exhibited higher shear strength than sample M2. When the vertical load was 50, 100, 200, and 400 kPa, the increases in shear strength were 8.84%, 12.05%, 13.19%, and 6.56%, respectively. The fitting relationship curve between vertical load and shear strength is shown in Fig. 14(j). The internal cohesion and internal friction angle of each group are presented in Fig. 14(k). For soil sample M2, the cohesion was 131.15 kPa and the internal friction angle was 51.42°, representing increases of 201.84% and 94.63%, respectively, compared to the unreinforced sample D2. For sample Z2, the cohesion was 154.60 kPa and the internal friction angle was 52.72°, corresponding to increases of 255.81% and 99.55%, respectively, relative to D2.
The formation of soil shear strength is primarily attributed to the precipitation of calcium carbonate on the surfaces of soil particles. The gradual accumulation of calcium carbonate precipitates on the particle surfaces creates bridges between adjacent particles, and the voids between particles are progressively filled38. The calcium carbonate precipitates not only enhance the overall integrity of the sample but also increase the surface roughness of particles. The soil consolidated with the isolated B. aryabhattai exhibited superior shear strength compared with that consolidated with S. pasteurii, further indicating that the isolated bacteria preferentially adhered to soil particles. This preferential adhesion facilitates the rapid formation and uniform distribution of calcium carbonate precipitates.
Disintegration rate
The disintegration test revealed that the uncured soil sample disintegrated rapidly in water, with a one-time disintegration rate of 100%. Upon initial immersion, the less cemented and uncemented soil particles detached first. With increasing disintegration cycles, the detached portion gradually extended from the bottom toward the interior, reflecting the incomplete and uneven consolidation of the sample. After a certain number of cycles, when water could no longer penetrate the interior and the strength of the cemented structure countered the gravity of the residual soil, the mass of the consolidated sample stabilized and remained largely intact3,39. The results of the antidisintegration test are shown in Fig. 14(l). For sample M2, the increments of the cumulative disintegration rate from the first cycle to the last were 4.065%, 3.454%, 1.756%, 1.416%, 0.96%, and 0.611%. For sample Z2, the corresponding increments were 3.994%, 3.07%, 1.219%, 1.107%, 0.693%, and 0.387%. These results indicate that after the second disintegration cycle, the disintegration rate of both consolidated soil samples tended to level off. The cumulative disintegration rate of sample Z2 over six cycles was 10.7%, which was slightly lower than that of sample M2 (12.26%), reflecting a better cohesion effect of soil particles after calcium carbonate precipitation bonding in sample Z2. This finding is consistent with the results of UCS and shear strength tests.
Evaluation of reinforcement effects by grouting method.
Analysis of the reinforcement effect of the spraying method
The experiment evaluated the solidification effects of two urease-producing bacteria on granite residual soil by measuring the resistance and calcium carbonate content of the reinforced soil samples. Schematic diagrams of the resistance and calcium carbonate content tests are shown in Fig. 15(a) and (c), respectively. In the experiment, regions I and III were reinforced with S. pasteurii, B. aryabhattai, and the cementation solution, whereas region II was sprayed with an equal amount of deionized water as a reference.
Resistance
The red and black clamps were attached to the two metal copper meshes, and the resistance value displayed on the digital bridge was recorded. Then, the positions of the clamps were swapped, the new resistance value was recorded again, and the average of the two measurements was taken. The resistance of the soil solidified by the spraying method was measured every 24 h over a period of 14 days.
As shown in Fig. 15(b), as calcium carbonate continued to form in regions I and III and as the grout gradually flowed out, the medium between the copper grids progressively transitioned toward a completely solid state. Consequently, the resistance values increased steadily. After a resting period of 14 days, the resistance value in region I was 973.811 Ω, that in region II was 4819 Ω, and that in region III was 752.150 Ω.
According to formula (2), resistance is inversely proportional to the cross-sectional area S of the propagation medium. As the reinforcement materials were of the same type and the environmental temperature remained constant, the influence of the medium’s resistivity can be neglected. Moreover, because the dimensions of the reinforced regions and the distance L between the copper meshes in each region were the same, the resistance value depended solely on the cross-sectional area S. Taking the resistance value of region II as the baseline, the resistance value of regions I and III decreased by 84.39% and 79.79%, respectively, indicating an effective improvement in the compactness of the soil sample after consolidation. This finding aligns with previous results, indicating that the isolated indigenous B. aryabhattai possesses an environmental adaptive advantage in consolidating granite residual soil, thereby achieving a more effective solidification outcome.
Production of calcium carbonate
Samples were taken from the upper and lower parts of the solidified soil samples consolidated with the two bacterial strains, and the calcium carbonate content was determined using the acid washing method, as shown in Fig. 15(c). The test results are presented in Fig. 15(d). As illustrated in the figure, the main difference in calcium carbonate content between the two bacterial strains in the consolidated soil sample appeared in the lower part. The calcium carbonate content in the lower part of the consolidated soil sample reinforced with B. aryabhattai was 6.28%, which was 36.22% higher than that of S. pasteurii at 4.61%. This confirms that B. aryabhattai can quickly adapt to the weakly acidic environment of the soil samples and rapidly attach to the lower part of the soil sample, thereby forming more abundant calcium carbonate precipitates. In contrast, S. pasteurii requires an increase in the soil sample pH as the MICP reaction progresses, enabling it to proliferate substantially and exert its high urease activity. This leads to the production of a large amount of calcium carbonate precipitates. Thus, the calcium carbonate content at the top of the soil sample reinforced with S. pasteurii was slightly higher than that of the soil sample reinforced with B. aryabhattai. It is worth noting that while the acid-washing method for quantifying calcium carbonate is a traditional, high-precision technique, it only provides the overall average content and fails to reveal its spatial distribution within the soil matrix. This limitation hinders an in-depth investigation into the MICP reinforcement mechanism. Additionally, since it measures all carbonate phases in the sample (including inherent soil carbonates), results may be overestimated40. In contrast, computed tomography visually clarifies calcium carbonate’s deposition sites, morphology, and distribution uniformity41. Integrating these methods to leverage their strengths and offset individual limitations is key to understanding the cementation mechanism and optimizing the grouting process.
Further microscopic observations were conducted on the solidified soil samples. As shown in Fig. 15(e)–(h), the upper portions of the soil samples consolidated with both bacterial solutions were relatively dense, although the calcium carbonate microstructures exhibited slight differences. In the sample solidified with S. pasteurii, the calcium carbonate precipitate displayed a regular calcite morphology, whereas in the sample solidified with B. aryabhattai, it showed a triangular cone shape. Microscopic analysis of the lower portions of the samples revealed that the calcium carbonate precipitates in S. pasteurii–treated samples were relatively loose, whereas those in B. aryabhattai–treated samples were densely packed in granular form. This disparity results in a higher overall density of the soil samples solidified with B. aryabhattai compared with those solidified with S. pasteurii.
Evaluation of reinforcement effects by spraying method.
Discussion
Reinforcement mechanisms
The urease activity of the strain is a crucial factor influencing the effectiveness of MICP in soil solidification, a fact that has been widely recognized in existing research. Adequate urease enables the rapid decomposition of urea, leading to the abundant formation of NH4+ and CO32–36,42. Al-Thawadi isolated six urease-producing bacteria with distinct characteristics from soil and conducted mineralization experiments43. Among them, the strain with the highest urease activity demonstrated the most potent mineralization capability. The urease activity of these bacteria is intricately linked to the yield, size, and morphology of CaCO3, which directly affects the efficiency of soil solidification43. Nevertheless, the impact of the solidified soil environment on the expression of high urease activity in bacterial strains warrants further consideration. For instance, the application of MICP in high-salinity environments became feasible only after the extraction of novel salt-tolerant microorganisms capable of high-yield enzyme production28. Furthermore, the desert-origin strain, Staphylococcus, forms mineralization layers with enhanced strength and stability, demonstrating the potential of MICP in desert environments44. These studies underscore the importance of isolating indigenous bacteria with high urease-producing capacity as a vital approach to enhancing the effectiveness of soil reinforcement. The B. aryabhattai isolated in this study exhibited urease activity of 36.55 mM/min, which is 6.69% lower than that of the reference strain (S. pasteurii). However, its solidification effect on granite residual soil surpassed that of S. pasteurii. S. pasteurii demonstrates relatively high enzymatic activity within the pH range of 8–9, aligning with the findings in Sect. “Comparative analysis of the growth characteristics of bacterial strains”. In contrast, in an environment with pH = 6, S. pasteurii requires approximately 30 h to transition into its normal growth phase. Consequently, the slightly acidic granite residual soil (pH = 5.3) significantly prolongs the time for S. pasteurii to reach the logarithmic growth phase, resulting in reduced reinforcement efficiency.
Figure 16 illustrates the urease-mediated MICP mineralization mechanisms. Bacterial-produced urease catalyzes the hydrolysis of urea, resulting in the release of CO2 and NH3. The hydrolysis of NH3 generates OH⁻, which elevates the solution pH and allows CO2 to exist as CO32⁻. The carbonate ions then react with free Ca2+ in the cementation solution, leading to the formation of CaCO3 precipitates45. Studies have indicated that in acidic environments, the MICP process slows down. Excess H+ ions trigger a reverse reaction of urea hydrolysis until they are neutralized by OH⁻ ions. This deceleration promotes more uniform bacterial distribution in the soil matrix, facilitating increased calcium carbonate precipitation46,47. However, in the present study, S. pasteurii did not demonstrate superior performance, and its reinforcement effect was less effective than that of the locally isolated strains. Based on the positive correlation between calcium carbonate distribution and reinforcement effectiveness, we infer two reasons: (1) Although the MICP process is slowed, S. pasteurii exhibits lower migration and adhesion capabilities in the soil compared to native strains, resulting in fewer bacterial cells distributed in the lower soil layers. (2) While urea hydrolysis gradually increases solution pH, creating a favorable growth environment for S. pasteurii, another issue emerges: excessively high urease activity reduces MICP efficiency. Specifically, when bacteria act as highly effective nucleation sites, they are rapidly encapsulated and inactivated by the calcium carbonate they produce. This not only causes rapid calcium carbonate accumulation in the upper soil layers (blocking the infiltration of bacterial suspensions and cementation solutions), but also reduces the number of active bacteria and their immediate enzyme activity. Consequently, only the upper soil layer is effectively reinforced48. This is the primary reason why the UCS failure mode of the test soil sample is characterized by bottom collapse.
Therefore, balancing urease activity with environmental adaptability is crucial for effective soil reinforcement. In weakly acidic soils, indigenously isolated strains maintain normal growth across pH 6–9. This adaptability facilitates a more uniform distribution of the strains in the soil, thereby enhancing urease activity, accelerating urea hydrolysis, completing the mineralization of CaCO3 deposition, and significantly improving the reinforcement effect.
Biocementation mechanism in MICP-treated soils.
Limitations and prospects
This study investigates the application of MICP to enhance weakly acidic soil. The environmental adaptability of the strain significantly influences the efficiency of its urease activity. Moreover, balancing the urease activity and environmental adaptability of strains is critical for effectively improving soil reinforcement. Notably, the temperature resilience of the strain is another key factor that influences this process. As discussed in Sect. “Comparative analysis of the growth characteristics of bacterial strains”, B. aryabhattai exhibited a prolonged lag phase at 20 °C. In contrast, the indigenously isolated B. aryabhattai demonstrates marked advantages in low-temperature resistance compared to S. pasteurii. However, this study did not systematically investigate the impact of variations in environmental temperature on MICP-treated soil samples. The combined effects of temperature and ambient pH on the efficacy of MICP soil reinforcement require further elucidation.
In this study, two types of reinforcement methods were employed. The spray reinforcement method primarily targets the solidification treatment of the top 5 cm of soil, effectively resisting rainwater erosion through surface compaction. Conversely, the grouting reinforcement method focuses on the solidification of the upper 20 cm of shallow soil. The experimental data provide valuable references for practical engineering reinforcement. However, the soil sample utilized in the laboratory tests is remolded soil, which deviates from the pore structure and water content of undisturbed soil. The remolding process alters the soil’s natural state in two critical aspects: (1) It disturbs the in-situ soil structure, forming a more homogeneous pore network with reduced structural strength, in contrast to the heterogeneous and typically more robust fabric of undisturbed soil; and (2) It enables precise control over initial water content, eliminating field moisture variability. Thus, while remolded samples provide essential consistency for comparative treatment evaluation, they may potentially overestimate compressibility and underestimate the true in-situ shear strength due to lost natural cementation and fabric. Additionally, parameters such as sample size and slope gradient were not considered. Therefore, conducting further field tests is essential for advancing the engineering application of MICP-reinforced granite residual soil49. Furthermore, a comprehensive evaluation of the durability of MICP-reinforced granite residual soil is necessary, particularly in light of the dynamic changes in the actual engineering environment, such as the typical dry-wet cycles in southern China, as well as short-term freeze-thaw cycles and acid rain50.
Conclusion
This study isolated indigenous urease-producing bacteria (B. aryabhattai) and conducted soil reinforcement experiments using spraying and grouting methods. The strengthening effects of S. pasteurii and B. aryabhattai were compared. The main findings are as follows:
-
(1)
The indigenous urease-producing bacterium B. aryabhattai exhibited an OD600 of 1.543 and a urease activity of 36.55 mM/min, which are lower than those of S. pasteurii. Additionally, the calcium carbonate induced by B. aryabhattai is the most stable calcite form.
-
(2)
B. aryabhattai demonstrated significantly broader environmental adaptability, with optimal growth at 20–40 °C and pH 6–9, compared to 30–40 °C and pH 8–9 for S. pasteurii.
-
(3)
Soil samples reinforced by grouting with B. aryabhattai and S. pasteurii exhibited considerable improvements compared with untreated soil samples (in term of ultrasonic wave velocity, UCS, cohesion, internal friction angle, and cumulative disintegration rates). These results demonstrate the superior performance of the isolated indigenous B. aryabhattai in grouting-reinforced soil samples.
-
(4)
Spraying with B. aryabhattai and S. pasteurii improved soil compactness, reducing resistance by 84.39% and 79.79% respectively compared to untreated soil. The lower part of B. aryabhattai-consolidated soil had a calcium carbonate content of 6.28%, 36.22% higher than that of S. pasteurii-treated soil (4.61%). These results confirm the isolated indigenous B. aryabhattai has significant advantages in soil spray reinforcement.
-
(5)
S. pasteurii shows a approximately 30 h prolonged lag phase in weakly acidic environments (pH 5.3) and only initiates normal growth and functional urease activity after soil pH increases to weakly alkaline levels via urea hydrolysis. In contrast, B. aryabhattai adapts rapidly to weakly acidic conditions and exhibits immediate urease functionality, which is critical for effective soil reinforcement.
Data availability
The datasets generated and analysed during the current study are available in the NBCI repository, [https://www.ncbi.nlm.nih.gov/nuccore/PX257993].
References
Zhao, Y., Chen, X., Wen, T., Wang, P. & Li, W. Experimental investigations of hydraulic and mechanical properties of granite residual soil improved with cement addition. Constr. Build. Mater. 318, 126016 (2022).
Zhan, L. et al. The 2015 Shenzhen catastrophic landslide in a construction waste dump: reconstitution of dump structure and failure mechanisms via geotechnical investigations. Eng. Geol. 238, 15–26 (2018).
Liu, X., Zhang, X., Kong, L., Wang, G. & Lu, J. Disintegration of granite residual soils with varying degrees of weathering. Eng. Geol. 305, 106723 (2022).
An, R., Kong, L., Li, C. & Luo, X. Strength Attenuation and microstructure damage of granite residual soils under hot and rainy weather. Chin. J. Rock Mechan. Eng. 39 (09), 1902–1911 (2020).
Sun, Y. & Tang, L. Use of X-ray computed tomography to study structures and particle contacts of granite residual soil. J. Cent. South. Univ. 26 (04), 938–954 (2019).
Gao, Y., Yang, S., Zhang, F. & Leshchinsky, B. Three-dimensional reinforced slopes: evaluation of required reinforcement strength and embedment length using limit analysis. Geotext. Geomembr. 44 (2), 133–142 (2016).
Zhang, F., Leshchinsky, D., Gao, Y. & Yang, S. Corner reinforced slopes: required strength and length of reinforcement based on internal stability. Geotext. Geomembr. 47 (3), 408–416 (2019).
Guo, H., Ng, C. W. W. & Zhang, Q. Three-dimensional numerical analysis of plant-soil hydraulic interactions on pore water pressure of vegetated slope under different rainfall patterns. J. Rock Mech. Geotech. Eng. 16 (9), 3696–3706 (2024).
Keybondori, S. et al. Soil-bioengineering to stabilize gravel roadside slopes in the steep hyrcanian forests of Northern Iran. Ecol. Eng. 214, 107569 (2025).
Naeimi, M. & Chu, J. Biocementation of sand dike against erosion due to overtopping. Acta Geotech. 18 (12), 6745–6757 (2023).
Cao, B. et al. The first microcapsule-based self-healing cement–bentonite cut-off wall materials. Geotechnique 73 (2), 105–114 (2021).
Zhang, X. et al. Improved methods, properties, applications and prospects of microbial induced carbonate precipitation (MICP) treated soil: A review. Biogeotechnics 3 (1), 100123 (2025).
Payan, M. et al. A comprehensive review on the application of microbially induced calcite precipitation (MICP) technique in soil erosion mitigation as a sustainable and environmentally friendly approach. Results Eng. 24, 103235 (2024).
Karimian, A. & Hassanlourad, M. Mechanical behaviour of MICP-treated silty sand. Bull. Eng. Geol. Environ. 81 (7), 285 (2022).
Yu, X. et al. Experimental study on microstructure of unsaturated expansive soil improved by MICP method. Appl. Sci. 12 (1), 342 (2021).
Li, J., Tian, L., Xu, Y., Tian, Z. & Zhang, Z. Study on the solidification effect of dredger fill by microbial-induced calcium precipitation (MICP). Materials 15 (22), 7891 (2022).
Fu, T., Saracho, A. C. & Haigh, S. K. Microbially induced carbonate precipitation (MICP) for soil strengthening: A comprehensive review. Biogeotechnics 1 (1), 100002 (2023).
Prajapati, N. K., Agnihotri, A. K. & Basak, N. Microbial induced calcite precipitation (MICP) a sustainable technique for stabilization of soil: A review. Mater. Today: Proc. 93, 357–361 (2023).
Wang, Y. et al. State-of-the-art review of soil erosion control by MICP and EICP techniques: Problems, applications, and prospects. Sci. Total Environ. 912, 169016 (2024).
Zhu, W. et al. Effect of calcium lignosulfonate on mechanical properties of fully weathered granite solidified by microorganism. China Civil Eng. J. 57 (03), 123–132 (2024).
Feng, D., Wang, Y., Chen, D. & Liang, S. Experimental study on the influence mechanism of clay particles on the microbial treatment of granite residual soil. Constr. Build. Mater. 411, 134659 (2024).
Wang, R. et al. Strength and mechanism of granite residual soil strengthened by microbial-induced calcite precipitation technology. Appl. Sci. 13 (15), 8863 (2023).
Yuan, B. et al. Addition of alkaline solutions and fibers for the reinforcement of kaolinite-containing granite residual soil. Appl. Clay Sci. 228, 106644 (2022).
Liu, S. et al. Effects of nitrogen sources on MICP-related metabolic mechanism of Sporosarcina pasteurii and soil reinforcement. J. Rock Mech. Geotech. Eng. 16 (12), 5147–5161 (2024).
Lapierre, F. M. & Huber, R. Revisiting the urease production of MICP-relevant bacterium Sporosarcina pasteurii during cultivation. Biocatal. Agric. Biotechnol. 55, 102981 (2024).
Teng, F., Sie, Y. C. & Ouedraogo, C. Strength improvement in silty clay by microbial-induced calcite precipitation. Bull. Eng. Geol. Environ. 80 (8), 6359–6371 (2021).
Saad, A. H. et al. Evaluating biosedimentation for strength improvement in acidic soil. Appl. Sci. 11 (22), 10817 (2021).
Yuan, Y. et al. Effect of microbially induced carbonate precipitation (MICP) in the highly saline silty soil of the cold plateau area of the Qinghai-Tibetan plateau. KSCE J. Civ. Eng. 26 (11), 4407–4418 (2022).
Vaskevicius, L. et al. Insights in MICP dynamics in urease-positive Staphylococcus sp. H6 and Sporosarcina pasteurii bacterium. Environ. Res. 234, 116588 (2023).
Ferris, F. G., Phoenix, V., Fujita, Y. & Smith, R. W. Kinetics of calcite precipitation induced by ureolytic bacteria at 10 to 20°C in artificial groundwater. Geochim. Cosmochim. Acta. 68 (8), 1701–1710 (2004).
Pailan, S., Gupta, D., Apte, S., Krishnamurthi, S. & Saha, P. Degradation of organophosphate insecticide by a novel Bacillus Aryabhattai strain SanPS1, isolated from soil of agricultural field in Burdwan, West Bengal, India. Int. Biodeterior. Biodegrad. 103, 191–195 (2015).
Ojha, S. K. et al. Response surface methodology based optimization and scale-up production of amylase from a novel bacterial strain, Bacillus Aryabhattai KIIT BE-1. Biotechnol. Rep. 27, e00506 (2020).
Shao, X., Li, X., Wang, H., Jia, Z. & Liu, C. Comparison and mechanism study on solidification of loose Pisha sandstone by Indigenous bacteria and Sporosarcina pasteurii. Case Stud. Constr. Mater. 21, e03844 (2024).
Tiwari, S., Prasad, V. & Lata, C. Chap. 3 - Bacillus: Plant Growth Promoting Bacteria for Sustainable Agriculture and Environment, in: J.S. Singh, D.P. Singh (Eds.), New and Future Developments in Microbial Biotechnology and Bioengineering, Elsevier 2019, pp. 43–55.
Qiu, Y. et al. Use of new bacterial strain in solidification and stabilisation of municipal solid waste incineration fly Ash. Environ. Geotechnics. 11 (3), 235–246 (2024).
Omoregie, A. I., Khoshdelnezamiha, G., Senian, N., Ong, D. E. L. & Nissom, P. M. Experimental optimisation of various cultural conditions on urease activity for isolated Sporosarcina pasteurii strains and evaluation of their biocement potentials. Ecol. Eng. 109, 65–75 (2017).
Li, W., Chen, W. S., Zhou, P. P., Cao, L. & Yu, L. J. Influence of initial pH on the precipitation and crystal morphology of calcium carbonate induced by microbial carbonic anhydrase. Colloids Surf., B. 102, 281–287 (2013).
Gebru, K. A., Kidanemariam, T. G. & Gebretinsae, H. K. Bio-cement production using microbially induced calcite precipitation (MICP) method: A review. Chem. Eng. Sci. 238, 116610 (2021).
Liu, X., Zhang, X., Kong, L., Wang, G. & Liu, H. Formation mechanism of collapsing gully in Southern China and the relationship with granite residual soil: A geotechnical perspective. CATENA 210, 105890 (2022).
Fan, W. et al. Effects of biostimulation treatment methods on mechanical properties and microstructure characteristics of biocemented soil. Acta Geotech. 20 (5), 2163–2184 (2025).
Zhang, M., Feng, C., He, X. & Xu, P. Analysis of the microstructure of microbial solidified sand and engineering residue based on CT scanning. Biogeotechnics 2 (1), 100054 (2024).
Dong, Y. et al. Optimization of growth conditions and biological cementation effect of Sporosarcina pasteurii. Constr. Build. Mater. 395, 132288 (2023).
Al-Thawadi, S. High strength in-situ biocementation of soil by calcite precipitating locally isolated ureolytic bacteria, Murdoch University (2008).
Li, C., Wang, S., Wang, Y. X., Gao, Y. & Bai, S. Field experimental study on stability of bio-mineralization crust in the desert. Rock. Soil. Mech. 40 (4), 1291–1298 (2019).
Dhami, N. K., Reddy, M. S. & Mukherjee, A. Biomineralization of calcium carbonate polymorphs by the bacterial strains isolated from calcareous sites. J. Microbiol. Biotechnol. 23 (5), 707–714 (2013).
Lai, Y. et al. Experimental study to improve the mechanical properties of iron tailings sand by using MICP at low pH. Constr. Build. Mater. 273, 121729 (2021).
Lai, H. J., Cui, M. J. & Chu, J. Effect of pH on soil improvement using one-phase-low-pH MICP or EICP biocementation method. Acta Geotech. 18 (6), 3259–3272 (2023).
Ramezani, Z., Farhangi, M. B., Ghorbanzadeh, N. & Shabanpour, M. Escherichia coli transport in two acidic soils: effect of microbially induced calcite precipitation technology. J. Contam. Hydrol. 269, 104493 (2025).
Liu, W. et al. Experimental study on Splash erosion resistance of granite residual soil improved by microbially induced carbonate precipitation. Soil Tillage. Res. 254, 106758 (2025).
Zhu, W. et al. Enhanced erosion resistance of granite residual soil through synergistic application of calcium lignosulfonate and microbial treatment. Eng. Geol. 355, 108256 (2025).
Acknowledgements
This work was supported by funding from the Natural Science Foundation of Fujian Province under Grant No. 2024J01912, the transportation Science and Technology Project of Fujian Province under Grant No. 202231. The authors gratefully acknowledge the English editing services provided by Ms. Qiannan Ma from Scientific Compass (www.shiyanjia.com).
Funding
This work was supported by funding from the Natural Science Foundation of Fujian Province under Grant No. 2024J01912, the transportation Science and Technology Project of Fujian Province under Grant No. 202231. The authors gratefully acknowledge the English editing services provided by Ms. Qiannan Ma from Scientific Compass (www.shiyanjia.com).
Author information
Authors and Affiliations
Contributions
Rong Wang, Chao Peng, and He Zhao wrote the main manuscript text; Rong Wang, Haixing Liu, and Lijuan Wang prepared all figures; Taibing Wei, and Huawei Li administrated the projects; All authors reviewed the manuscript.
Corresponding authors
Ethics declarations
Competing interests
The authors declare no competing interests.
Additional information
Publisher’s note
Springer Nature remains neutral with regard to jurisdictional claims in published maps and institutional affiliations.
Rights and permissions
Open Access This article is licensed under a Creative Commons Attribution-NonCommercial-NoDerivatives 4.0 International License, which permits any non-commercial use, sharing, distribution and reproduction in any medium or format, as long as you give appropriate credit to the original author(s) and the source, provide a link to the Creative Commons licence, and indicate if you modified the licensed material. You do not have permission under this licence to share adapted material derived from this article or parts of it. The images or other third party material in this article are included in the article’s Creative Commons licence, unless indicated otherwise in a credit line to the material. If material is not included in the article’s Creative Commons licence and your intended use is not permitted by statutory regulation or exceeds the permitted use, you will need to obtain permission directly from the copyright holder. To view a copy of this licence, visit http://creativecommons.org/licenses/by-nc-nd/4.0/.
About this article
Cite this article
Wang, R., Peng, C., Zhao, H. et al. Strengthening mechanisms of indigenous bacteria in granite residual soil improvement via microbial induced calcite precipitation. Sci Rep 16, 2782 (2026). https://doi.org/10.1038/s41598-025-32718-z
Received:
Accepted:
Published:
Version of record:
DOI: https://doi.org/10.1038/s41598-025-32718-z